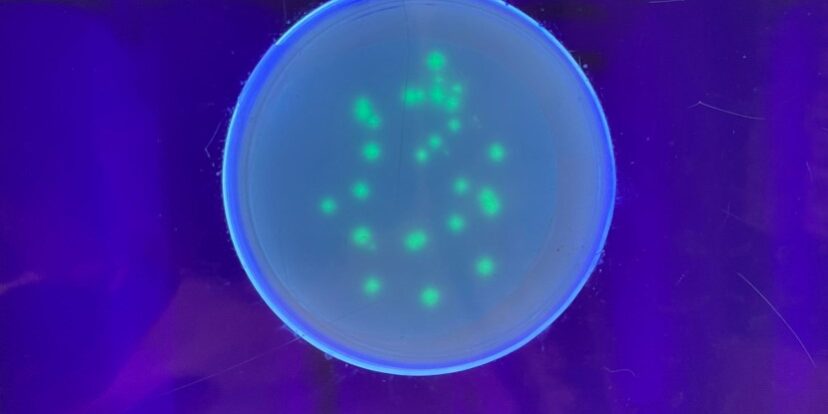
La tecnologia del DNA ricombinante: dai batteri alle nuove frontiere della biotecnologia

La tecnologia del DNA ricombinante: dai batteri alle nuove frontiere della biotecnologia
Aggiungi Nuovo IFT - Istituto di Farmacologia Traslazionale
169 169 people viewed this event.
La tecnologia del DNA ricombinante consiste nel prelevare alcuni segmenti di DNA da un organismo e inserirli in un altro, della stessa specie o di specie diversa. La tecnologia del DNA ricombinante ha creato una vera e propria rivoluzione scientifica ed ha permesso la nascita delle biotecnologie moderne con loro enorme potenziale di impiego in diversi settori.
Illustreremo come i batteri rappresentano un mezzo perfetto al servizio della biotecnologia e come è possibile creare e produrre in laboratorio molecole di enorme utilità come l’insulina o il TGF.
A cura di : Giovanna Montana; Annalisa Pinsino; Simona Taverna.